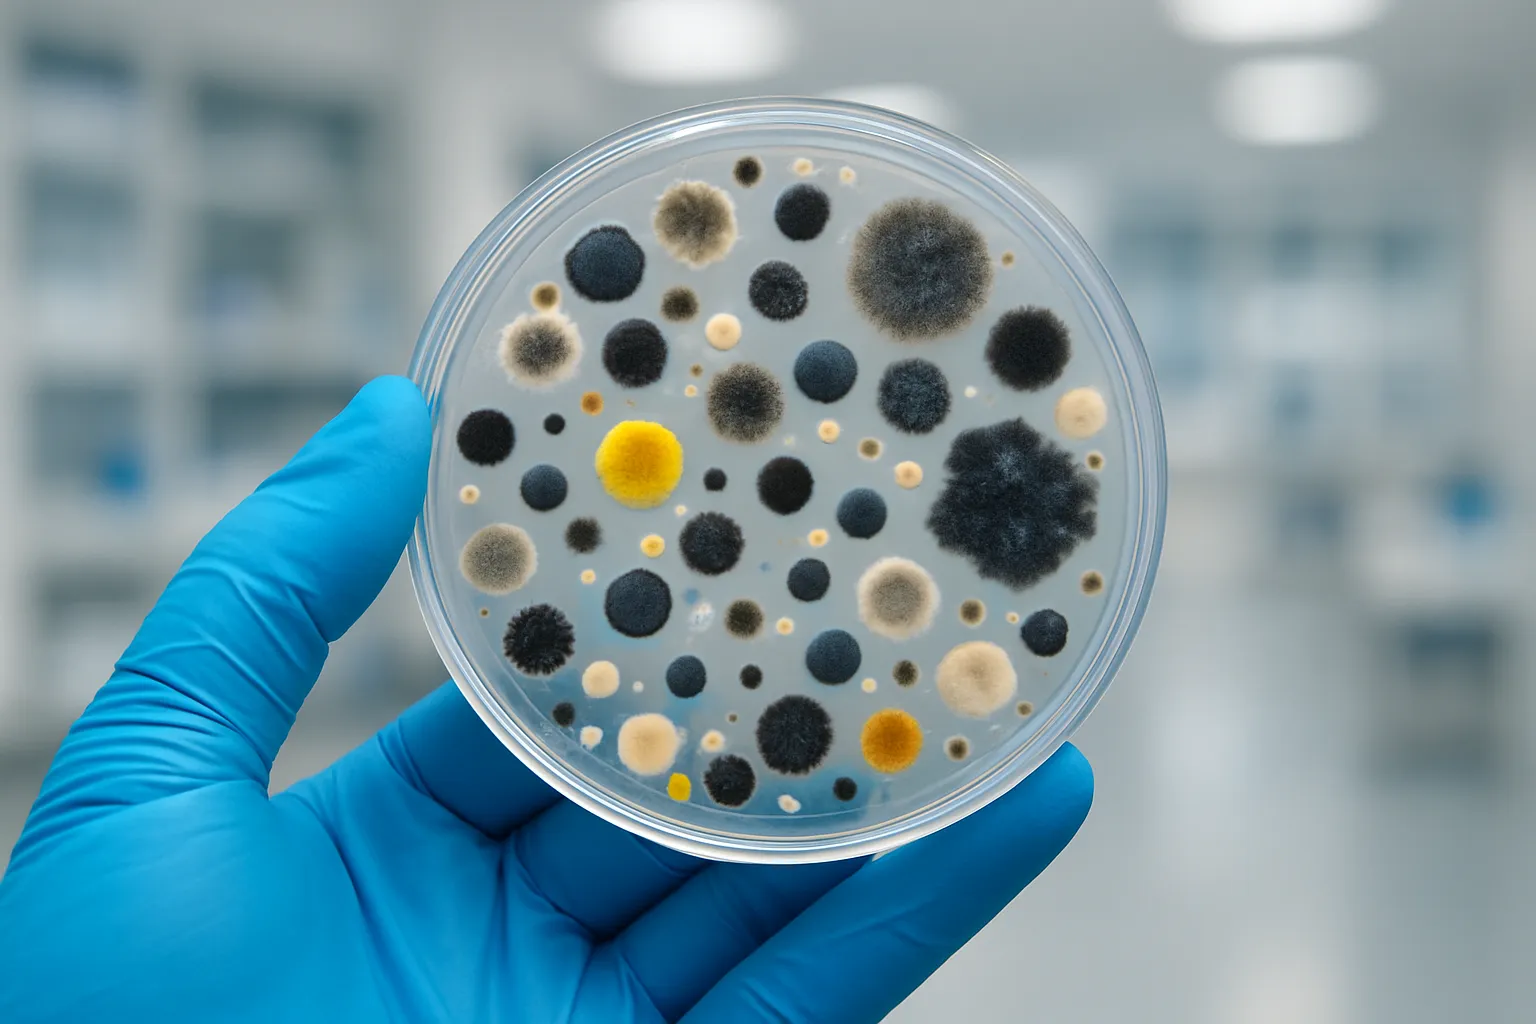

Mold Testing and Inspection in Seattle
Call us, we are here to help.
To book Testing and Inspection for your home or business, Click Here. You can also call us at 1-888-462-4763 or 1-888-GO-AIRMD.
Kathryn D.
I'm so, so glad I came across this company. I can't say enough good things from the very first call, to the actual indoor fungal assessment conducted and explained to me by Alexandria. I'd absolutely recommend to anyone who has any suspicion of mold issues or water event.
Joe L.
We decided to get AirMD to do a mold inspection and glad we did! Christian is an excellent technician and pointed out spots that were suspect. He took the time to explain to us his procedure and how we can fix the situation in the future. Hurricane Ian left his mark in the form of water spots on our ceiling, mold on the attic side.

Professional Mold Testing Services in Seattle, WA
Seattle's persistent rainfall and high humidity create ideal conditions for mold growth in homes and commercial buildings throughout King County. Our certified mold testing specialists use advanced scientific methods to detect both visible and hidden mold contamination before it compromises your indoor air quality or triggers health symptoms. Professional mold assessment protects your family's respiratory health while identifying moisture intrusion sources that could damage building materials and reduce property values. Washington State's strict indoor air quality standards require proper documentation when mold issues are discovered, making professional testing essential for compliance and insurance claims. Our comprehensive testing reveals the full scope of contamination, from surface growth to airborne spores, ensuring you have the complete picture needed for effective remediation. Don't wait for musty odors or visible growth to appear - early detection saves money and protects health. Contact our certified specialists at 1-888-462-4763 to schedule professional mold testing that meets Washington's regulatory requirements.
Why Seattle Properties Need Mold Testing
Seattle's marine climate brings over 150 rainy days annually, creating persistent moisture challenges in buildings ranging from historic Capitol Hill homes to modern South Lake Union condominiums. The Pacific Northwest's mild temperatures and high humidity levels provide year-round conditions for mold growth, particularly in basements, crawl spaces, and poorly ventilated areas common in older Seattle construction. King County's diverse building stock, including century-old craftsman homes and newer construction, each presents unique moisture vulnerability points that require professional assessment. Washington State regulations mandate proper mold disclosure in real estate transactions, while local building codes emphasize moisture control and indoor air quality standards. Professional testing identifies hidden contamination behind walls, under flooring, and in HVAC systems before health symptoms develop or structural damage occurs. Contact our certified mold specialists at 1-888-462-4763 for comprehensive testing that protects your Seattle property investment.
Comprehensive Mold Testing Services Throughout the Seattle Area
Our certified mold testing services cover all of Seattle and surrounding King County communities, including Bellevue, Redmond, Kirkland, and Tacoma, using EPA-approved sampling methods and independent laboratory analysis. We conduct systematic visual inspections, air quality sampling, surface testing, and advanced moisture detection to identify both active growth and conditions supporting future contamination. Our state-certified technicians utilize professional-grade equipment including thermal imaging cameras, moisture meters, and air sampling pumps to detect hidden problems in walls, crawl spaces, and HVAC systems. Each comprehensive assessment includes detailed documentation meeting Washington State disclosure requirements and insurance claim standards. We provide clear remediation recommendations, from simple DIY solutions for minor issues to detailed contractor specifications for complex problems, ensuring appropriate response without unnecessary expansion of work. Our rapid turnaround delivers results within 48 hours, complete with actionable next steps. Schedule your professional mold assessment today by calling 1-888-462-4763 for thorough testing throughout the greater Seattle metropolitan area.
Protecting Seattle Families and Workers from Mold Exposure
Mold exposure poses serious health risks to Seattle residents, particularly those with allergies, asthma, or compromised immune systems, causing respiratory irritation, eye problems, and persistent coughing that worsens over time. Professional mold testing prevents long-term health consequences by identifying contamination before symptoms develop, protecting children and elderly family members who are most vulnerable to airborne toxins. DIY mold testing kits cannot detect hidden growth behind walls or accurately identify dangerous species like black mold, potentially leaving families exposed to ongoing health hazards. Our certified specialists use laboratory-grade equipment and scientific sampling methods to provide accurate results that protect your family's wellbeing and meet Washington State health standards. Early professional detection prevents minor moisture problems from becoming major health crises and costly remediation projects. Don't gamble with your family's health when professional testing provides definitive answers and peace of mind. Call 1-888-462-4763 now to schedule comprehensive mold testing that safeguards your Seattle home and protects everyone who lives and works there.Get your Free Ebook
Get expert insights download the E-Book now!
Gain practical tips, proven strategies, and industry knowledge—all packed into one powerful resource.
